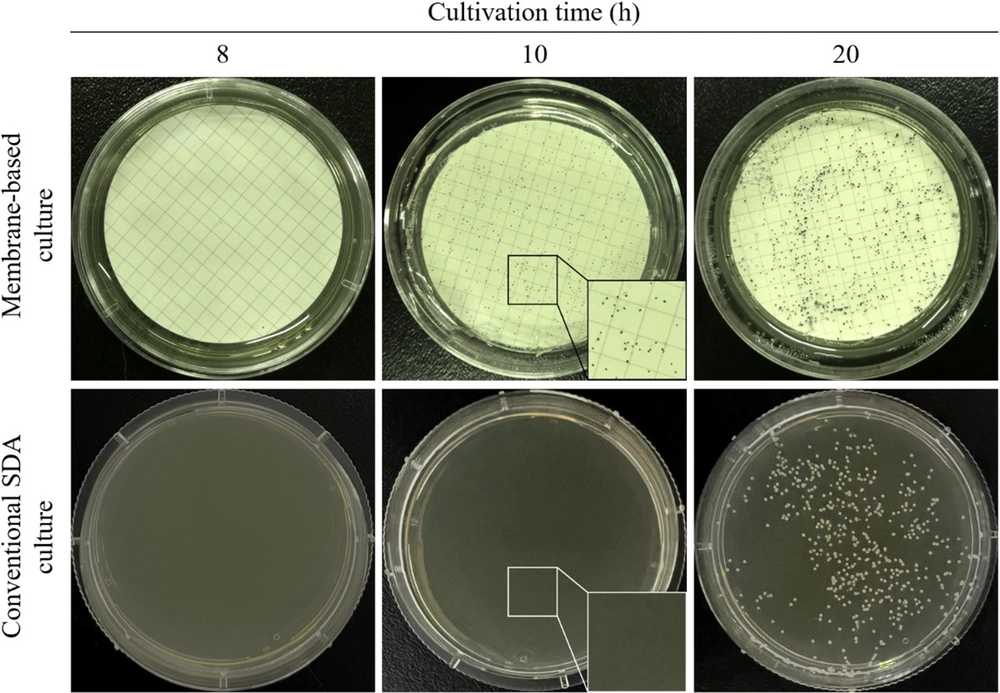

1. Background
Severe mucocutaneous and invasive fungal diseases have become the most common fungal infections in immunocompromised and critically ill patients and have a high rate of morbidity and mortality (1-3). Globally, Candida albicans remains the predominant pathogen, causing superficial and life-threatening invasive candidiasis (IC), but the infection rate of non-albicans Candida (NAC) species has increased in recent years (4). Apart from C. albicans, the three major NAC species that account for IC are C. tropicalis, C. glabrata, and C. krusei (3). In many geographic regions around the world, IC cases caused by NAC species have exceeded 50%. Notably, NAC species are generally more resistant to commonly used antifungal drugs than C. albicans (1, 5). Antifungal resistance is also an increasingly difficult challenge for implementing effective empirical and prophylactic strategies. Timely and accurate species-level identification of Candida is important because antifungal susceptibility patterns are varied among these species, and proper differentiation helps select appropriate antifungal drugs for prevention and treatment.
Today, the conventional culture method of detecting IC is heavily time-consuming, requiring a 24 - 48 hour incubation period before identification (6, 7). The majority of patients with IC do not receive antifungal therapy until yeast is detected in a culture, and many of them are not placed on the appropriate therapy until the Candida species is identified. It has been estimated that every 12 hours of delay before initiating antifungal therapy is associated with a 22% increase in the patient mortality rate and additional costs in healthcare (8). In addition to the prolonged time for detection inherent in cultures, it is also clear that the existing methods for common Candida species identification and differentiation are cumbersome, often inaccurate, device-dependent, and too slow to provide results within the critical 12- to 24-hour treatment window (9). Future antifungal surveillance should incorporate the goals of developing and adapting tools suitable for use in low- and middle-income countries and increasing the availability of rapid and simple fungal identification techniques suitable for local clinical laboratories (10).
2. Objectives
The purpose of the present study was to integrate the membrane-based cultivation with melting temperature (Tm) analysis following dual-target real-time polymerase chain reaction (PCR) to develop a short-term, cost-effective, high-resolution approach to Candida species differentiation. The entire process is expected to be completed within 10 - 12 hours.
3. Methods
3.1. Reference Strains and Clinical Isolates
Reference strains of C. albicans (ATCC 10231), C. tropicalis (ATCC 750), C. glabrata (ATCC 36583), and C. krusei (ATCC 6258) were obtained from American type culture collection (ATCC, Manassa, VA, USA). A total of 72 clinical Candida isolates were gifted from Hangzhou Third People’s Hospital, Hangzhou, China, that had been identified by Candida chromogenic medium (CHROMagar, Paris, France) and internal transcribed spacer (ITS) ribosomal DNA sequencing (Table 1). The reference strains and clinical isolates were cultured on Sabouraud dextrose agar (SDA; Haibo, Qingdao, China) with 25 μg/mL chloramphenicol (Sigma-Aldrich, St. Louis, MO, USA) or cultured at 30°C in a yeast extract-peptone-dextrose medium (YPD; Sangon Biotech, Shanghai, China) at 30°C for 48 hours. To analyze the growth rate of these samples from different body sites, the supernatant of each centrifuged isolate was discarded, while the pellet was washed twice with sterile phosphate-buffered saline (PBS; Sangon Biotech) and then resuspended in 5 mL of YPD medium. The turbidity of the suspension was adjusted and standardized spectrophotometrically to an initial optical density (OD600) of 0.019, which is equivalent to 2 × 104 cells/mL. After incubation at 30°C, the absorbance at 600 nm was detected at the indicated times with a Tecan Spark microplate reader (Tecan Group Ltd., Männedorf, Switzerland).
| Isolate and Source of Isolation | Number of Isolates | Isolates Color-tested | Isolates Sequenced |
|---|---|---|---|
| Candida albicans | C. albicans (n = 33) | C. albicans (n = 33) | |
| Sputum | 24 | ||
| Throat swab | 5 | ||
| Urine | 2 | ||
| Bronchoalveolar lavage fluid | 1 | ||
| Peritoneal fluid | 1 | ||
| C. tropicalis | C. tropicalis (n = 29) | C. tropicalis (n = 29) | |
| Sputum | 19 | ||
| Urine | 7 | ||
| Throat swab | 2 | ||
| Stool | 1 | ||
| C. glabrata | C. glabrata (n = 6) | C. glabrata (n = 6) | |
| Sputum | 5 | ||
| Throat swab | 1 | ||
| C. krusei | C. krusei (n = 2) | C. krusei (n = 2) | |
| Sputum | 2 | ||
| C. parapsilosis | C. glabrata (n = 2) | C. parapsilosis (n = 2) | |
| Tissue | 2 |
3.2. Membrane-based Cultivation
The membrane-based cultivation device had two components, consisting of a membrane-based plate and an indicator plate. The membrane plate was a 50-mm SDA (Haibo) plate covered with a white cellulose microporous membrane (Huankai, Shenzhen, China) with a thin film of nutrient agar on the surface. The indicator plate was made of a 50-mm plate with a non-nutrient agar color indicator. The microfiltration membrane enabled the exchange of water and nutrients but was non-penetrative to yeast cells. The color indicator agar plate consisted of 0.8 mg/mL thiazolyl blue tetrazolium bromide (Sigma-Aldrich) (11). Metabolism of the dye by yeast led to coloration (dark blue) and subsequent visualization of the microcolonies. A schematic diagram of the membrane-based cultivation is shown in Figure 1.
Cultures of all Candida strains were grown for 24 hours on an orbital shaker at 200 rpm in 10 mL of YPD at 30°C. After the concentration was adjusted to 1 × 108 cells/mL for all isolates, each yeast culture was serially diluted 10-fold in sterile PBS through 10-3. For the negative control, sterile YPD was serially diluted in PBS in the same manner. For all the Candida samples, 10 μL aliquots of each dilution were spread on both a membrane-based plate and a conventional SDA plate. The plates were incubated for 2, 4, 6, 8, 10, 20, and 30 hours, after which the membrane was aseptically peeled from the membrane plate, transferred to an indicator plate, and incubated at room temperature until dark blue colonies were visible approximately 3 minutes. As a control to determine whether the membrane-based plate could also be used qualitatively for rapid yeast culture isolation and identification, the Candida plated onto the SDA plate was incubated in parallel for the same amount of time at 30°C. The dark-blue microcolonies of the yeast were visualized and counted, and colony-forming units (CFUs)/mL were determined. All data were expressed as mean log10 CFU/mL using triplicate samples.
3.3. Template DNA Preparation
The extraction of genomic DNA for colony real-time PCR was performed as previously described (12). Briefly, the yeast cells from a dark-blue colony on the indicator plate were suspended in 20 μL of Y-PER yeast protein extraction reagent (Thermo Fisher Scientific, Waltham, MA, USA) or 0.2% sodium dodecyl sulfate (SDS, Sigma-Aldrich). The mixture was vortexed for 10 seconds to lyse the cells, and the mixture was incubated at 98°C for 5 minutes. The lysate was centrifuged at 12,000 g, and the supernatant was collected, diluted with distilled water at a 1:5, 1:10, 1:15, or 1:20 dilution ratio, and then used as a DNA template in subsequent PCR analyses.
3.4. Melting Analysis Following Dual-target Real-time PCR
The primers for dual-target real-time PCR were selected, as shown in Table 2. All primers were synthesized by Sangon Biotech (Shanghai, China). The 25 μL of reaction mixture consisted of 12.5 μL of 2 × TB Green Premix Ex Taq (Takara Bio, Beijing, China), 1 μL of each forward and reverse primer (0.2 μM) of the primer set CALB or CAND, 2 μL of the DNA template (approximately 100 ng) from each of the Candida reference strains or the 72 clinical Candida isolates, and 8.5 μL of distilled water. The dual-target real-time PCR and the melting analysis were performed using a CFX Connect thermocycler (Bio-Rad, Hercules, CA, USA).
The experimental conditions used were as follows: 30 seconds at 95°C, followed by 35 cycles of 5 seconds at 95°C, 5 seconds at 55°C, and 5 seconds at 72°C. Subsequently, a melting analysis was performed, and the temperature was ramped from 60°C to 95°C at a rate of 0.1°C/second. Melting curves were analyzed by CFX Maestro 2.3 software (Bio-Rad). The thresholds for each real-time PCR assay were determined by the CFX software (Bio-Rad) with default settings. For each PCR run, a set of DNA samples consisted of 100 pg, 10 pg, 1 pg, 100 fg, 10 fg, and 1 fg of DNA from each target Candida species, 1 ng of DNA from common pathogenic bacteria, Aspergillus, humans (13, 14), and no-template control (NTC). Reactions were run in triplicate, and the amplicons were confirmed by agarose gel electrophoresis.
Abbreviations: F, forward primer; R, reverse primer; NAC, non-albicans Candida.
a The primers CALB-F/R and CAND-F/R correspond to “CALB-1/2” and “Candida-F/R” in the original references, respectively.
3.5. Agarose Gel Electrophoresis
YeaRed nucleic acid gel stain (Yeasen, Shanghai, China) was loaded into a 1.5% agarose gel in TAE buffer (40 mM Tris-acetate, 1 mM EDTA, pH 8.3), and the electrophoresis was performed at 110 V for 40 minutes in a standard horizontal electrophoresis unit. DNA was observed under a UV gel imaging system (Bio-Rad), and images were collected after electrophoresis.
3.6. Statistical Analysis
The SPSS Statistics 25.0 software (SPSS Inc., Chicago, IL, USA) was used for statistical analysis, and the results were presented as mean ± standard deviation (SD) based on independent experiments for each set. A P-value of < 0.05 was considered significantly different.
4. Results
4.1. Candida Clinical Isolates from Different Body Sites Present Similar Growth Profiles
Figure 2 displays the growth curves of the Candida clinical isolates, which were sampled from different body sites and cultured under normal growth conditions. A comparison of the growth curves of the Candida isolates showed that the growth characteristics of Candida from the different sources tended to be similar. As the growth curves show, the lag, log, and stationary phases are clearly exhibited. Regardless of which part of the body the sample was obtained, it took about 8 to 10 hours for the yeasts to adapt to the normal growth environment before they were ready to proliferate and enter the log phase.
Growth curves of the Candida clinical isolates sampled from different body sites and cultured under YPD medium at 30°C were characterized by a sigmoidal growth curve pattern, indicating an orderly increase in cell mass. The values were expressed as the mean ± SD from three independent experiments. The abbreviations in the legend represent different Candida species and different sampling sources: Candida albicans from sputum (Cal-SP), C. albicans from throat swab (Cal-TS), C. albicans from urine (Cal-UR), C. albicans from bronchoalveolar lavage fluid (Cal-BL), C. albicans from peritoneal fluid (Cal-PF), C. tropicalis from sputum (Ctr-SP), C. tropicalis from urine (Ctr-UR), C. tropicalis from throat swab (Ctr-TS), C. tropicalis from stool (Ctr-ST), C. glabrata from sputum (Cgl-SP), C. glabrata from throat swab (Cgl-TS), C. krusei from sputum (Ckr-SP), and C. parapsilosis from tissue (Cpa-TI).
4.2. Membrane-based Cultivation Reduces the Time Needed to Detect Candida Colonies
Compared with the colonies observed after cultivation on a conventional SDA plate for 20 hours, the membrane-based cultivation shortened the time to the appearance of visible colonies of C. albicans ATCC 10231 to 10 hours (Figure 3), reducing the culture time by approximately 50%. The results in Table 3 show that the colonies on the membrane-based plate were visible and could be counted after culturing for 10 hours, and the counting results were similar to those after culturing for 20 and 30 hours. Furthermore, the colony counting results after 20 hours had considerable similarity with those of the conventional SDA culture. The time to detect Candida colonies with the membrane-based culture was significantly shortened. The negative plate showed no colony growth. The other NAC species in this research also showed similar results in the membrane-based culture and conventional SDA culture (data not shown).
A comparison of the colony visibility of the membrane-based culture was conducted with the conventional Sabouraud dextrose agar (SDA) culture of the Candida albicans (American type culture collection (ATCC) 10231) strain after incubation for 8, 10, and 20 hours. The yeast colonies (dark-blue spots) on the indicator plates of the membrane-based culture were visible after 10 hours of incubation (the inset in the upper middle panel shows a partially zoomed-in view of the dark-blue colonies, and no colony growth can be seen in the inset that shows a partially enlarged view of the lower middle panel).
| Cultivation Time (h) | Mean Colony Count | |
|---|---|---|
| Membrane-based Culture | Conventional SDA Culture | |
| 10 | 2.969 ± 0.017 | Uncountable |
| 20 | 3.021 ± 0.031 | 3.032 ± 0.013 |
| 30 | 3.015 ± 0.021 | 3.024 ± 0.026 |
Abbreviations: SD, standard deviation; SDA, Sabouraud dextrose agar.
a Values are expressed as log ± SD unless otherwise indicated.
4.3. Thiazolyl Blue in Colonies Does Not Affect the PCR Assay
The Candida colony stained with thiazolyl blue was directly lysed and used as a template for PCR analysis, and the results are shown in Appendix 1. The results suggested that the colony stained with thiazolyl blue did not affect the PCR assay. Although the reaction with the 1:5 lysate was negative, the lysates of the other three dilutions all amplified a single band, and the product size was consistent with the expected result. The negative PCR with the 1:5 lysate may be due to the high concentration of the lysate in the reaction.
4.4. The Specificity of the Melting Analysis for the Candida Species
Melting analysis following dual-target real-time PCR was performed with four Candida reference strains. The melting peaks were obtained by taking the first derivative of the fluorescence signal produced in the PCR assay by each set of primers. The results showed that the identification of each Candida species was confirmed jointly by two independent melting peaks. Each of the curves was unimodal, and their corresponding melting peaks were clearly distinguishable (Figure 4). For each species of Candida, the combination of dual melting peaks formed by the primer sets CALB and CAND in the real-time PCR presented different morphological characteristics due to their different Tm values, which facilitated a rapid distinction between species. The Tm ranges (mean ± SD) formed by the primer set CALB for the reference strains of C. albicans, C. tropicalis, C. glabrata, and C. krusei were 85.50 ± 0.06°C, 76.52 ± 0.04°C, 75.56 ± 0.13°C, and 75.12 ± 0.12°C, which are significantly different (P < 0.05).
Dual melting peak analysis of amplicons from a real-time polymerase chain reaction (PCR) assay was performed using the primer set CALB, which targets the 5.8S rDNA region, and CAND, which targets the internal transcribed spacer 2 (ITS2) region. Dual melting curve of Candida albicans (Cal) (A); C. tropicalis (Ctr) (B); C. glabrata (Cgl) (C); or C. krusei (Ckr) (D) was observed. In each panel, the red and green lines represent the melting curves generated by real-time PCR with the primer sets CALB and CAND, respectively. The purple and grey lines represent the curve of the no-template control (NTC). The abscissa of the melting curve represents temperature, and the ordinate (-d(RFU)/dT) is the negative derivative of the fluorescence intensity with respect to temperature.
The Tm ranges of the primer set CAND for these four Candida species were 81.57 ± 0.09°C, 78.53 ± 0.05°C, 80.47 ± 0.05°C, and 85.60 ± 0.08°C, which are significantly different (P < 0.05). The primer set CALB distinguished C. albicans from the NAC species easily, and the primer set CAND distinguished different species of Candida from each other. The maximum Tm variations with the CALB and CAND primer sets across the four reference strains were 10.38°C and 7.07°C in triplicate assays, respectively, and the minimum Tm variations with the CALB and CAND primer sets against the four strains were 0.44°C between C. glabrata and C. krusei, and 1.10°C, between C. albicans and C. glabrata, respectively. The melting curves following the dual-target real-time PCR presented a unique combination of melting peaks, which we deemed suitable for discriminating among the four reference strains. In the assay, no amplification was observed with the negative control or NTC (no melting peak observed). Moreover, the primer sets CALB and CAND for detecting Candida genomic DNA had a detection limit of 10 fg and 1 fg, respectively.
4.5. Melting Analysis of Clinical Isolates of the Four Candida Species
For the amplification curves of the clinical isolates, each set of primers showed a matching range of significantly different Tm values (P < 0.05) from those of the reference strains following the dual-target real-time PCR (Table 4). Although there were slight variations among different strains within each species, they may be too close to make reliable distinctions between species. Moreover, since each isolate was jointly identified by the two characteristic peaks of the melting curve generated by the two primer sets, the impact of a small variation in a single Tm value on species identification was also minimized. Compared with the original identification results of the isolates from ITS sequencing, the results of the melting analysis following the dual-target real-time PCR were completely consistent (Table 5).
| Candida Species | Tm Value a (°C) | Number of Clinical Isolates (n) | |
|---|---|---|---|
| CALB | CAND | ||
| Candida albicans | 85.75 ± 0.27 | 81.55 ± 0.22 | 33 |
| C. tropicalis | 76.33 ± 0.44 | 78.68 ± 0.24 | 29 |
| C. glabrata | 75.88 ± 0.35 | 80.40 ± 0.31 | 6 |
| C. krusei | 75.75 ± 0.21 | 85.73 ± 0.25 | 2 |
a Values are expressed as mean ± SD.
| Species | Melting Analysis | Sequencing |
|---|---|---|
| Candida albicans (n = 33) | C. albicans (n = 33) | C. albicans (n = 33) |
| C. tropicalis (n = 29) | C. tropicalis (n = 29) | C. tropicalis (n = 29) |
| C. glabrata (n = 6) | C. glabrata (n = 6) | C. glabrata (n = 6) |
| C. krusei (n = 2) | C. krusei (n = 2) | C. krusei (n = 2) |
| C. parapsilosis (n = 2) | Not applicable | C. parapsilosis (n = 2) |
a The overall agreement between melting analysis and sequencing of internal transcribed spacer (ITS) was 100%.
5. Discussion
Although C. albicans is the main causative agent of mucocutaneous and IC infections, those caused by other common NAC species are also on the rise. Of note, clinical outcomes indicate that non-albicans species are generally more resistant to antifungal agents than C. albicans (17). Triazoles are the drugs of choice for the treatment and prevention of Candida infections. It has been reported that the resistance rate of C. tropicalis to the triazoles fluconazole and voriconazole exceeds 20%, the resistance rate of C. glabrata to voriconazole is close to 50% in recent years, the resistance rate of C. albicans to triazole antifungal drugs is approximately 5 - 10%, and innate fluconazole resistance has been identified in C. krusei (5, 18). Rapid and accurate identification of Candida species is critical for antifungal infection treatment. The conventional culture method is the gold standard for Candida identification, but its time-consuming nature has always been a major problem in clinical applications (5).
The Candida chromogenic culture method is commonly used in clinical examination, in which the tested strains are grown on a chromogenic medium with visible colonies after 24 - 48 hours (19). Therefore, empirical antifungal therapy is still very common. The main purpose of this study was to develop a new method that would retain the advantages of the culture method while enriching the samples through short-term culture, combined with dual-target melting analysis to efficiently differentiate common Candida species, thus reducing the time needed to initiate targeted treatment for patients with severe candidiasis. There was no need for prolonged incubation of samples with the micro-level template requirements of a PCR-based assay. This research demonstrated a method in which yeast samples were cultured on a microporous membrane pre-coated SDA plate for up to 10 hours, and then the membrane was transferred to an indicator plate containing thiazolyl blue. As shown in Figure 2, it took approximately 8 to 10 hours for the Candida isolates from different parts of the body to enter the log phase. The detection time did not vary significantly according to the different strain sources. The colonies appeared dark blue within 3 minutes.
The coloring substance thiazolyl blue interacted with the succinate dehydrogenase in the yeast to produce dark-blue formazan, which colored the colonies and improved the sensitivity for visual inspection (Figure 3). Furthermore, the results of this research suggested that the thiazolyl blue-stained colonies did not affect the release of template DNA during lysis. However, to reduce the impact of the lysate components on subsequent real-time PCR, the lysate should be diluted no less than 10 times. The nutritional status of Candida in the membrane-based culture was consistent with conventional SDA culture. When cultured with conventional SDA for the first 10 hours of growth, the generated colonies were small, and the contrast between the natural white colonies and the light-colored background of the culture medium was correspondingly low, making it difficult to distinguish colonies by visual inspection. When using a membrane-based culture plate combined with thiazolyl blue, the contrast between the dark blue-stained colonies and the white background of the membrane was significantly increased, making it convenient for observation by the naked eye. After culturing for 10 hours, the colonies were sufficiently large for observation, even though they were grown on a conventional SDA plate.
Membrane-based cultivation was no longer necessary at this point. It can be seen that the advantage of the membrane-based culture lies in the early observation and early sampling of the Candida culture. In this study, a visible colony was selected and used in the next process, real-time PCR-based melting analysis and the entire detection time was found to be 12 hours shorter than the conventional culture method. If using a low-powered microscope combined with micromanipulation, it is possible to find and pick dark-blue colonies at an even earlier time point, and this research approach is expected to further reduce the overall time required and generate higher predictive power than the conventional culture method. The membrane-based culture involved in this research was reported previously for the application of bacterial colony counting, but with that study, a special commercial pre-coated film plate was needed. Unlike the previously reported study, in this study, a common microporous membrane was added to the surface of an ordinary SDA plate, which can significantly reduce the cost. In addition, microbial identification after colony counting was not included in the previous study (11).
It is well known that the clinical treatment of Candida infection, especially severe infection, is a race against time, and the results of this study are undoubtedly of great significance for improving the current situation in this regard. Inappropriate empiric therapy can be minimized through early identification of Candida species. To shorten the overall Candida identification cycle, this research integrated short-term membrane-based cultivation and convenient real-time PCR. As shown in previous studies, real-time PCR followed by melting analysis simplifies PCR-based technologies, avoids external nucleic acid contamination and postprocessing, such as electrophoresis or enzymatic digestion, and enables the identification of amplicons directly by specific melting peaks (20-23).
The versatility and specificity of primers are very critical in real-time PCR-based melting analysis, and therefore primers in this research were selected in the coding region of the Candida ribosomal DNA gene, in which the sequence is both conserved and diverse. Universal primer amplicons from different Candida species may have similar lengths but most likely have significantly different Tm values due to the differing GC content. It was also the original intention of this study to combine specific melting peaks with specific Tm values to distinguish different common Candida species.
A single primer set may be difficult to judge accurately due to less pronounced differences among individual primers or possible variations in Tm values between samples in the melting analysis. This research demonstrated that dual-target PCR using two sets of specific Candida primers improved the resolution of differentiation for the common Candida species. The purpose of using the primer set CALB was similar to previous reports (14, 24), which was the identification of C. albicans from NAC species. It was originally designed as a species-specific primer set to identify C. albicans by targeting the 5.8S ribosomal DNA region (14, 15). Although the primer set CALB was used for the analysis of Candida species in a recent study (25), there is no clear report on the melting analysis of the amplicons for each species, except for the Tm value of C. albicans. In this research, it was found that the melting peak (Tm = 85.75°C) of the primer set CALB against C. albicans was similar to that described in a previous study (15) and was either clearly distinguished from the Tm values of the other three Candida species detected or had a higher fluorescence intensity due to a better match between the primers and target. In addition to the primer set CALB, the primer set CAND was used for further identification of NAC species, which has been used as a set of pan-Candida primers to identify Candida species in previous studies (16).
Based on the Candida nucleotide sequences published on the NCBI website, the PCR product size of C. albicans, C. tropicalis, C. glabrata, and C. krusei amplified by primer set CAND is 328 bp, 318 bp, 407 bp, and 336 bp, respectively. The corresponding GC content is 54.27%, 46.64%, 49.63%, and 56.85%, which matches the results of the melting temperature analysis following real-time PCR of the four Candida strains in the present research. Using the primer set CAND to distinguish Candida species in this study; we obtained Tm values that were similar to previous studies (14); however, there were also small Tm value differences in each species, which may be due to slight changes in gene sequences caused by species phylogeny and evolution (26, 27). Although the Tm values generated by primer set CAND for C. albicans and C. glabrata differed only slightly from each other (approximately 1°C), the distinction of each strain increased notably when combined with the melting peak using the primer set CALB (Figure 4 and Table 4).
Interestingly, in the 72 clinical isolates tested here, two Candida isolates were initially identified as C. glabrata by the commercial chromogenic media. However, they showed a different melting peak position from that of the C. glabrata reference strain in the melting analysis of this research. After DNA sequencing, the two strains were confirmed as C. parapsilosis. C. glabrata and C. parapsilosis produce similarly colored cultures when grown on chromogenic media, which can make it difficult to distinguish between the two strains. This work may improve the resolution of Candida species differentiation through confirmation by dual-target detection.
5.1. Conclusions
The integrated technique established here, which utilized short-term membrane-based cultivation combined with dual-target melting analysis, identified common Candida species more rapidly and accurately than other culture-based methods. It is expected to retain the advantages of the culture methods and improve upon their weaknesses while reducing the time needed to initiate targeted treatment of patients with severe candidiasis.